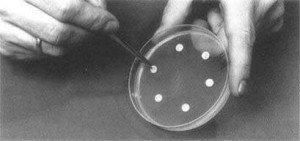
Mueller Hinton Agar - Placing antibiotic disc in Mueller-Hinton agar medium

Mueller-Hinton agar (MHA)  is the best medium for routine antimicrobial susceptibility testing using the Kirby-Bauer disc diffusion method for non-fastidious bacteria (aerobe and facultative anaerobe). The use of media other than Mueller-Hinton agar may result in erroneous results.
MHA is also the standard medium used for most broth dilution testing as the conditions of this medium (i.e. pH, cation concentration, and thymidine contents) are well maintained.
MHA can be purchased from commercial suppliers or can also be prepared from the dehydrated medium. Be sure to prepare the media according to the manufacturer’s directions.
Composition

The formula for Mueller-Hinton agar per liter of purified water
- Beef extract: 2.0 g
- Acid Hydrolysate of casein: 17.5 g
- Starch: 1.5 g
- Agar: 17.0 g
Preparation
Mueller-Hinton agar
- Weigh appropriate amount of dehydrated Mueller-Hinton agar powder (follow manufacturer’s instructions on bottle) and place in a 2-liter flask.
- Add 1 liter of distilled water and swirl to disperse powder.
- Place over a hot plate with a magnetic stirrer (or other heating devices) and heat until powder is dissolved (bring to a gentle boil). Do not boil vigorously, and do not apply direct heat without stirring, as medium will burn.
- Carefully remove agar from heat and dispense in desired aliquots into containers of choice (e.g., dispense 250-ml volumes into 500-ml Erlenmeyer flasks).
- Loosely cover containers (e.g., insert stopper into mouth of flask).
- Autoclave at 121°C for 15 min.
- Allow to cool in a 48°C water bath.
- Arrange sterile Petri plates on a level surface to give uniform depth.
- For disk diffusion tests, pour accurately measured volumes of molten agar into plates*.
60 to 70 ml/150-mm plate 25 to 30 ml/100-mm plate
- Eliminate bubbles on the molten agar surface by quickly (and carefully) passing the flame from a Bunsen burner over the agar.
- Allow plates to solidify at room temperature with plate lids slightly ajar.
- Check prepared MHA to ensure the final pH is 7.3 ±1 at 25°C. Note:If the pH is <7.2 certain drugs will appear to lose potency (aminoglycosides, quinolones, macrolides), while other agents may appear to have excessive activity (tetracycline). If the pH is >7.4, the opposite results may occur.
- Store prepared plates at 2 to 8°C in tightly sealed packages.
*Note: The correct depth of Mueller-Hinton agar for disk diffusion testing is critical. Failure to dispense accurate volumes may result in agar that is too thin (often yielding false-susceptible results) or too thick (often yielding false-resistant results).
Sheep blood (5%)-supplemented Mueller-Hinton agar
- Prepare 1 liter of MHA as described above.
- Add 50 ml of sterile defibrinated sheep blood to molten and cooled (48°C) agar.
- Gently swirl to mix and pour plates as described above.
- Store prepared plates at 2 to 8°C in tightly sealed packages.
Quality Control
When a new lot of media is prepared, do the following checks to ensure the quality of the prepared media.
- Sterility checks,
- Measurement of pH
- Measurements of fill (volume, depth, etc.)
- Performance checks
Test the MHA with the below-mentioned strains of organisms at least weekly in order to verify that the media and disks are working as expected. Check the zone of inhibition and compared it with CLSI-defined ranges. The susceptibility results must fall within CLSI-defined ranges.
QC strain(s) for performance test of Mueller Hinton Agar
- Escherichia coliATCC 25922
- Staphylococcus aureus ATCC 25923
- Pseudomonas aeruginosaATCC 27853
- Enterococcus faecalisATCC 29212
- Streptococcus pneumoniae ATCC 49619 (for Mueller-Hinton agar with 5% sheep blood)
Why Mueller-Hintonagar for AST?

Mueller-Hinton agar is the best medium for routine antibiotic susceptibility testing (AST) because of the following reasons:
- It shows acceptable batch-to-batch reproducibility for susceptibility testing
- It supports satisfactory growth of most nonfastidious pathogens
- It is low in sulfonamide, trimethoprim, and tetracycline inhibitors (i.e. concentration of inhibitors thymidine and thymine is low in MHA)
- A large body of data and experience has been collected concerning susceptibility tests performed with this medium.
Modifications of Muller Hinton agar
- Mueller Hinton agar medium supplemented with 5% sheep blood is recommended for determining the antimicrobial susceptibility of
Streptococcus pneumoniae Neisseria meningitidis
- Haemophilus test medium (HTM) is the preferred medium for the antimicrobial susceptibility testing of H. influenzae using the modified Kirby Bauer disk diffusion method. HTM medium consists of the following ingredients: thymidine-free MHA supplemented with 15 ÎĽg/ml NAD, 15 ÎĽg/ml bovine hemin, and 5 mg/ml yeast extract.
Limitations
- Not all clinically significant aerobic isolates that require antimicrobial susceptibility testing grow satisfactorily in the Mueller-Hinton agar.
- Sometimes supplements may have an inactivating effect on the antimicrobial agents tested. Supplements that have not been extensively studied should be used with caution. Always test QC reference strains in the medium used for testing patient isolates. Results must fall into specified ranges for the test to be acceptable.
- There may be variations in the performance of media obtained from different manufacturers or different lots from the same manufacturer.
References and further readings
- Andrea J. Linscott, 2016. Â *Clinical Microbiology Procedures Handbook,*4th Edition. ASM Press, Washington, DC. doi: 10.1128/9781683670438.
- CLSI. Performance Standards for Antimicrobial Susceptibility Testing. 30th ed. CLSI supplement M100. Wayne, PA: Clinical and Laboratory Standards Institute; 2020.
- Bailey & Scott’s Diagnostic Microbiology, Forbes, 11th edition
- Koneman’s Color Atlas and Textbook of Diagnostic Microbiology (Color Atlas & Textbook of Diagnostic Microbiology), 7th edition